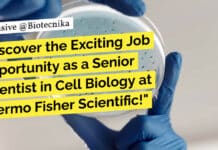
Discover the Exciting Job Opportunity as a Senior Scientist in Cell Biology at Thermo Fisher Scientific! "Discover the Exciting Job Opportunity as a Senior Scientist in Cell Biology at Thermo Fisher Scientific!"

Exclusive Opportunity: High-Paying Job for Biotech BTech Graduates at CSMCRI – Apply Now!
BTech Biotech JRF at CSMCRI - Applications Invited
The Central Salt and Marine Chemicals Research Institute (CSMCRI) is a premier national laboratory under the Council...
Exciting Job Opportunity at National Brain Research Centre – Apply Now for this Agricultural...
National Brain Research Centre Agricultural Sciences Project Job - Applications Invited
NATIONAL BRAIN RESEARCH CENTRE (NBRC) invites applications for the post of “Project Associate I...
Exciting Job Opportunity in Agricultural Sciences at NBRC – Apply Now!
NBRC Agricultural Sciences Project Associate Job - Applications Invited
Advertisement No. : Acad. /14/2023
Dated: 27.12.2023
NATIONAL BRAIN RESEARCH CENTRE (NBRC) invites application to the post of...
Hiring Alert: Research Associate Position at Syngene For MSc Life Sciences – Apply Now!
Syngene Research Jobs Life Sciences - Apply Online
Syngene (www.syngeneintl.com) is an innovation-led contract research, development, and manufacturing organization offering integrated scientific services from early...
Reliance Life Sciences Hiring! Biotech, Biochem & Microbiology Attend Walk-In
Reliance Life Sciences Hiring! Biotech, Biochem & Microbiology Walk-In
We welcome women returning to the workforce post a career break.
Reliance Life Sciences is a medical...
Calling All Biotech and Microbiology Experts! Reliance Life Sciences Walk-In Drive – Get Ready!
Reliance Life Sciences Walk-In Drive!
We are Hiring for Nashik and Navi Mumbai
Biosimilars
Welcome to Reliance Life Sciences Walk-In Drive! We are currently seeking qualified individuals...
Exciting Job Opportunity in Applied Biology and Biotech – Join ICMR-NIIH Research Team in...
ICMR-NIIH Applied Biology, Biotech, Life Sciences Research Recruitment
Indian Council of Medical Research (ICMR) - National Institute of Immunohaematology (NIIH)
The ICMR-NIIH in Mumbai is currently...
Apply Now! Life Sciences AIIMS Delhi JRF Job – Predicting Cancer with AI and...
Life Sciences AIIMS Delhi JRF Job Recruitment - Applications Invited
DEPARTMENT OF HEMATOLOGY
ALL INDIA INSTITUTE OF MEDICAL SCIENCES
New Delhi 110029
Applications are invited for the position...
Ferrero Rocher Hiring Microbiologists! Apply Online
Ferrero Rocher Hiring Microbiologists! Apply Online
SENIOR MICROBIOLOGIST
Job Location: Baramati
About Ferrero Rocher
Ferrero is a family-owned company with a truly progressive and global outlook and iconic...
Discover the Exciting Job Opportunity as a Senior Scientist in Cell Biology at Thermo...
Thermo Fisher Cell Biology Scientist Job - MSc, PhD Life Sciences Apply
Senior Scientist I, Cell Biology
About Company:
Thermo Fisher Scientific Inc. is the world leader...
Hot Job Alert: Intas Pharmaceuticals Hiring – Apply Now!
Opportunities with Intas Pharmaceuticals
About Intas Pharmaceuticals
Intas Pharmaceuticals is a leading global pharmaceutical company committed to making healthcare accessible to all. With a focus on...
Exciting Government Job Opportunities at CDSCO in Biotech, Genetics, Mol Bio & Immunology –...
Govt CDSCO Vacancies For Biotech, Genetics, Mol Bio & Immunology
F. No. D.21013/60/2023-DC
Government of India
Directorate General of Health Services
Central Drugs Standard Control Organization
(Administration Division)
VACANCY NOTICE
The...
Discover Your Dream Job in Agricultural Sciences at CSIR-IMTECH – Apply Now!
CSIR-IMTECH Agricultural Sciences Recruitment - Apply Online
Rolling advt. no.12-06
Position: Project Associate-I = 01
Essential Qualification: Master’s Degree in Natural or Agricultural Sciences/ MVSc or Bachelor’s...
Attention Biotech, Biochem, and Microbiology Experts! Don’t Miss Out on Zydus Biologics QA Jobs...
Zydus Biologics QA Jobs For Biotech, Biochem, Microbiology - Attend Walk-In
Inviting candidates for Executive / Sr. Executive posts for
Zydus Biologics (Zydus Biotech Park), Ahmedabad...
Hurry! Mega Recruitment Drive at Zydus Research Centre – Multiple Positions Available for MSc,...
Mega Recruitment Drive at Zydus Research Centre For MSc, MTech, PhD
Inviting candidates for a walk-in
interview for multiple openings at
Zydus Research Centre, Ahmedabad
on 7th January,...